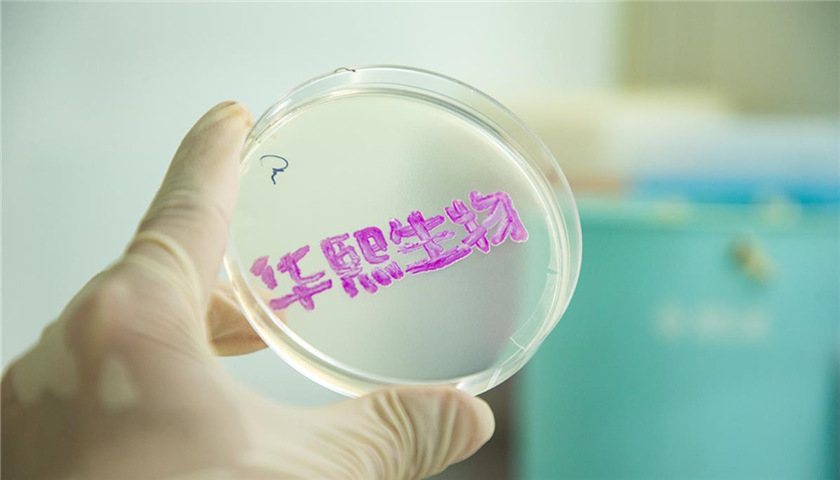

文 | 牛星钧
10月28日,华熙生物发布2025年第三季度报告。报告显示,公司第三季度实现营业收入9.03亿元,同比下降15.16%;实现归属于上市公司股东的净利润3152.85万元,同比增长55.63%,延续了第二季度以来的利润恢复趋势。
2025年前三季度,公司累计实现营业收入31.63亿元,同比下降18.36%;归属于上市公司股东的净利润2.52亿元,同比下降30.29%。
这一净利润数据,与华熙生物此前在2025年半年度报告中的披露数据相比,降幅有所收窄。
华熙生物在公告中表示,2025年3月份以来,公司董事长兼总经理赵燕带领管理团队重回业务一线,持续对经营理念、业务方向及人才组织模式进行系统性调整,推动经营质效持续改善。
销售费用率的大幅下降是华熙生物三季度利润改善的关键因素。华熙生物第三季度销售费用率降至34.26%,为近五年来最低水平,这被其解释为“品牌沟通模式与渠道结构优化的结果”。
与此同时,华熙生物继续加大研发投入。第三季度研发投入合计1.30亿元,同比增长15.58%;研发投入占营业收入的比例达到14.41%,同比增加3.83个百分点。
前三季度累计研发投入达3.61亿元,同比增长15.37%,研发投入占营业收入比例为11.42%。
目前,华熙生物正在推进业务结构的战略性调整,以合成生物制造能力为基础,构建“原料终端产品”一体化业务布局,聚焦衰老干预领域。原料与医疗终端业务成为核心业绩基础,约占华熙生物整体收入的60%,保持稳健发展趋势。
在生物科技竞争日益激烈的当下,华熙生物能否凭借其“科研+品牌”双轮驱动构建持续优势,仍需市场检验。



评论